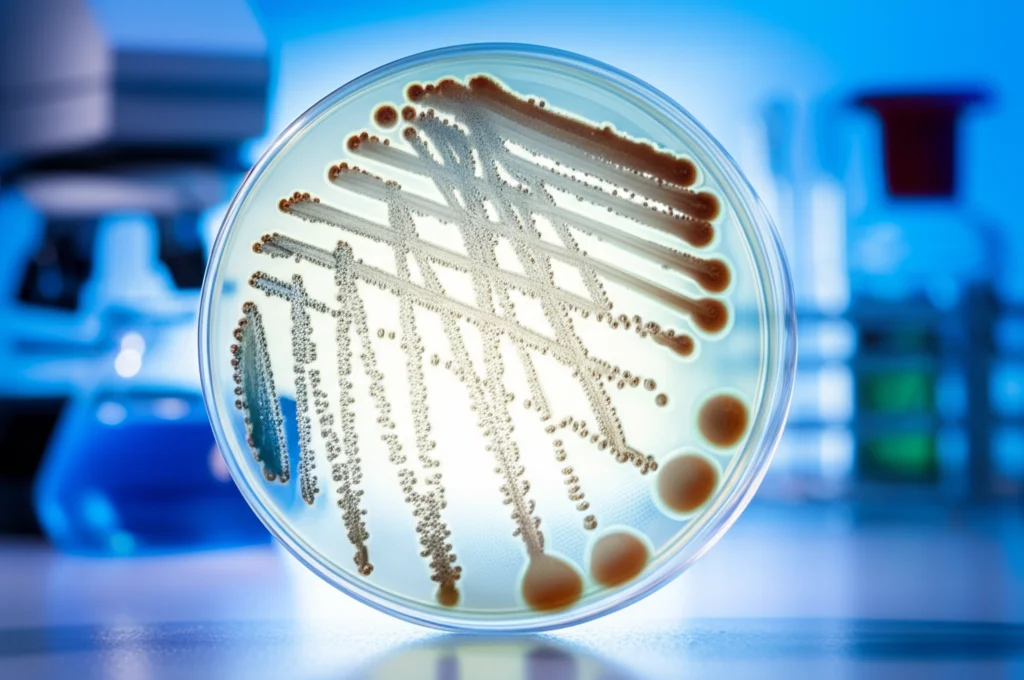
Microbiologia: Piastra di Petri con colonie batteriche di Moraxella catarrhalis, vista macro, obiettivo 90mm, alta definizione, illuminazione controllata da laboratorio, sfondo sfocato di attrezzature scientifiche.

Moraxella Catarrhalis: Vi Svelo i Segreti del Batterio che Colpisce i Polmoni dei Bambini
Ciao a tutti! Oggi voglio parlarvi di un “personaggio” un po’ misconosciuto nel mondo dei batteri, ma che in realtà gioca un ruolo da protagonista, non sempre positivo, nella salute dei nostri bambini: la Moraxella catarrhalis. Magari il nome non vi dice molto, ma fidatevi, è più comune di quanto pensiate e può causare un bel po’ di problemi, soprattutto alle vie respiratorie dei più piccoli.
Recentemente, ho avuto modo di approfondire uno studio affascinante condotto nella provincia dello Shandong sudoccidentale, in Cina. L’obiettivo? Capire meglio chi è questa Moraxella, come si comporta, quanto è “cattiva” (in termini tecnici, la sua patogenicità) e come risponde agli antibiotici, analizzando anche un suo particolare “superpotere”: il gene Bro, legato alla resistenza. Perché è importante? Beh, conoscere il nemico è il primo passo per combatterlo efficacemente, aiutando i medici a fare diagnosi più rapide e precise e a scegliere la terapia giusta.
Un Nemico Nascosto: Chi è Moraxella Catarrhalis?
Pensate che questo batterio, un diplococco Gram-negativo (una definizione tecnica per descriverne forma e reazione a una colorazione specifica), è stato identificato per la prima volta nel lontano 1896! Per decenni è stato considerato un semplice “inquilino” innocuo delle nostre vie respiratorie. Poi, negli anni ’70, abbiamo iniziato a capire che tanto innocuo non era. Oggi sappiamo che è la terza causa batterica più comune di infezioni delle basse vie respiratorie (LRTIs) nei bambini, dopo i più “famosi” Streptococcus pneumoniae e Haemophilus influenzae.
Non si limita ai polmoni: è spesso responsabile di otiti medie (il classico mal d’orecchio dei bimbi) e sinusiti. Negli adulti, soprattutto quelli con problemi respiratori cronici come la BPCO, può causare riacutizzazioni. Insomma, un batterio da non sottovalutare.
La Nostra Indagine nello Shandong: Cosa Abbiamo Scoperto?
Lo studio che ho analizzato è stato condotto tra il 2018 e il 2021 (anche se i dati clinici coprivano dal 2020 al 2023 per alcuni aspetti) e ha esaminato campioni provenienti da bambini con infezioni delle basse vie respiratorie. Immaginate la mole di lavoro: su oltre 10.000 campioni analizzati, la Moraxella catarrhalis è stata trovata in 848 casi, con una percentuale di rilevamento complessiva del 7,81%. Non poco!
Ma la cosa più interessante è stata vedere chi colpisce di più e quando.
- Età: I più vulnerabili sono risultati i lattanti tra i 28 giorni e 1 anno di vita, con un tasso di infezione del 9,69%. Nei neonati (sotto i 28 giorni) la percentuale era più bassa (5,34%), forse grazie agli anticorpi materni. Man mano che i bambini crescono, l’incidenza cala (7,11% tra 1 e 6 anni, e solo 0,44% tra 6 e 14 anni), probabilmente per la maturazione del sistema immunitario.
- Stagionalità: C’è un picco evidente! La Moraxella sembra amare il freddo. Il tasso di rilevamento più alto si è registrato nel quarto trimestre dell’anno (autunno-inverno), raggiungendo l’11,58%. Questo ha senso: l’aria fredda e secca indebolisce le nostre difese respiratorie, stiamo più spesso in luoghi chiusi e affollati (favorendo la trasmissione) e magari circolano anche altri virus che spianano la strada al nostro batterio.
- Genere: Nessuna differenza significativa tra maschietti (8,11%) e femminucce (7,29%).
Da Sola o in Compagnia? Le Co-infezioni
Nella maggior parte dei casi (quasi l’80%), la Moraxella agiva da sola. Ma nel restante 20% circa, è stata trovata in “cattiva compagnia”, associata ad altri batteri come lo Streptococcus pneumoniae e l’Haemophilus influenzae. Queste infezioni miste sono particolarmente ostiche. Perché? La Moraxella, come vedremo tra poco, produce un enzima (la β-lattamasi) che può distruggere alcuni antibiotici, proteggendo indirettamente anche i suoi “compagni di merende” batterici che sarebbero sensibili a quegli stessi farmaci. Inoltre, insieme possono formare dei biofilm, una specie di “scudo” protettivo che li rende ancora più resistenti alle terapie e alle difese del nostro corpo.
Il Grosso Problema: La Resistenza agli Antibiotici
E qui arriviamo a un punto cruciale e, devo dire, preoccupante. Abbiamo testato la sensibilità della Moraxella a 13 diversi antibiotici. I risultati?
- Buone Notizie: C’è ancora speranza! Tutti i ceppi isolati erano completamente sensibili a ceftazidime, cefepime e imipenem (antibiotici potenti, spesso usati in ospedale). Anche verso ciprofloxacina, levofloxacina, ceftriaxone, cefuroxime, tetraciclina e cloramfenicolo la sensibilità era molto alta (superiore al 95%). Questo è probabilmente dovuto al fatto che alcuni di questi farmaci sono usati con più cautela nei bambini.
- Cattive Notizie: Le resistenze a farmaci comunissimi sono alle stelle. Oltre il 93% dei ceppi era resistente all’ampicillina (un tipo di penicillina) e addirittura oltre il 99% alla clindamicina.
- Notizie Preoccupanti: La resistenza all’eritromicina (un macrolide, classe di antibiotici molto usata per le infezioni respiratorie pediatriche, a volte anche troppo!) è aumentata drasticamente nel periodo dello studio: dal 69,73% nel 2018 è schizzata al 90,57% nel 2021. Un campanello d’allarme enorme! Questo riflette probabilmente un uso eccessivo e non sempre appropriato di questa classe di antibiotici nella regione.

L’Arma Segreta della Moraxella: β-Lattamasi e Gene Bro
Ma come fa la Moraxella a resistere così bene, specialmente alle penicilline come l’ampicillina? La sua arma principale è la produzione di un enzima chiamato β-lattamasi. Questo enzima è capace di “rompere” la struttura chimica di alcuni antibiotici (quelli chiamati β-lattamici, appunto), rendendoli inefficaci.
Nello studio, ben il 96,58% dei ceppi di Moraxella isolati produceva β-lattamasi! E siamo andati anche a vedere quale “versione” di questo enzima producessero, analizzando il gene responsabile, chiamato gene Bro. Esistono principalmente due varianti: Bro-1 e Bro-2. Indovinate quale dominava? Il Bro-1, trovato nel 94,51% dei ceppi produttori di β-lattamasi. Il Bro-2 era presente solo nel 5,49%. Perché è importante saperlo? Perché il Bro-1 sembra essere più “efficiente” nel distruggere gli antibiotici rispetto al Bro-2.
Questa massiccia produzione di β-lattamasi (soprattutto Bro-1) spiega l’altissima resistenza all’ampicillina, ma fortunatamente, come abbiamo visto, non intacca (per ora) l’efficacia di cefalosporine di generazione più avanzata o dei carbapenemi.
Cosa Ci Insegna Tutto Questo? Implicazioni Cliniche
Questi risultati non sono solo numeri su un foglio, ma hanno implicazioni concrete per medici, genitori e per la salute pubblica.
- Terapia Empirica: Quando un bambino arriva con una sospetta infezione respiratoria batterica, spesso il medico inizia una terapia “empirica”, cioè basata sui patogeni più probabili, prima di avere i risultati delle analisi. Bene, questi dati ci dicono chiaramente che usare ampicillina o macrolidi (come l’eritromicina) come prima scelta potrebbe essere del tutto inutile contro la Moraxella in quella regione, data l’elevata resistenza. Meglio orientarsi su combinazioni di β-lattamici con inibitori delle β-lattamasi (come amoxicillina-acido clavulanico) o su cefalosporine di terza generazione.
- Monitoraggio Continuo: È fondamentale continuare a monitorare l’evoluzione delle resistenze e la diffusione dei geni Bro. La situazione può cambiare rapidamente.
- Antimicrobial Stewardship: Bisogna usare gli antibiotici con più giudizio! Soprattutto nei bambini e nei lattanti, e specialmente durante la stagione invernale. Programmi mirati per promuovere un uso appropriato degli antibiotici (antimicrobial stewardship) sono essenziali per preservare l’efficacia dei farmaci che ancora funzionano.
- Identificazione Rapida: Strumenti diagnostici moderni come la spettrometria di massa MALDI-TOF, usata nello studio, permettono un’identificazione rapida e affidabile del batterio, aiutando a scegliere la terapia mirata più velocemente.
- Speranza nei Vaccini: La ricerca sta lavorando allo sviluppo di vaccini contro la Moraxella catarrhalis, mirando a proteine presenti sulla sua superficie. Sarebbe un passo avanti enorme per prevenire le infezioni e ridurre l’uso di antibiotici.

Limiti e Prospettive Future
Come ogni studio, anche questo ha i suoi limiti. È stato condotto in un solo centro, quindi i risultati potrebbero non essere generalizzabili a tutta la Cina o ad altre parti del mondo. Inoltre, essendo retrospettivo, si basa su dati già raccolti, e la pandemia di COVID-19 potrebbe aver influenzato la raccolta dei campioni in un certo periodo.
Cosa serve ora? Sicuramente studi multicentrici più ampi, magari utilizzando tecniche avanzate come il sequenziamento dell’intero genoma per capire ancora meglio le relazioni tra i diversi ceppi, i loro geni di resistenza e virulenza, e come questi si collegano all’uso degli antibiotici sul territorio.
In conclusione, la Moraxella catarrhalis è un batterio che merita tutta la nostra attenzione, specialmente in ambito pediatrico. Questo studio cinese ci ha fornito dati preziosi sulla sua diffusione, sui gruppi più a rischio, sulla stagionalità e, soprattutto, sui preoccupanti livelli di resistenza agli antibiotici comuni. È un chiaro invito a non abbassare la guardia, a usare gli antibiotici in modo più responsabile e a investire nella ricerca per nuove strategie di prevenzione e trattamento. Teniamola d’occhio!
Fonte: Springer
